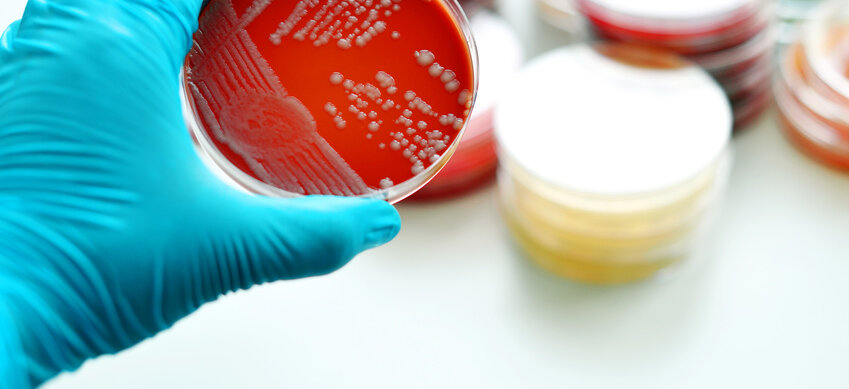
Petrischalen mit Bakterienkulturen

Antibiotika | Resistenzen
TÜCKISCHE KEIME
Seite 1/1 1 Minute
Die 70-jährige Frau aus Nevada bekam bereits im August vergangenen Jahres die Diagnose eines Sepsis-ähnlichen Krankheitsbildes: Systemisches inflammatorisches Response-Syndrom (SIRS). Auslöser war ein Serom in der rechten Hüfte, in dem sich Lymphflüssigkeit und Blutserum sammelte. In diesem hatte sich ein Carbapenem-resistentes Enterobakterium (CRE) eingenistet; einen Tag nach der Diagnose isolierten die Ärzte Klebsiella pneumoniae aus einer Wunde der Frau. Dieser Keim war resistent gegen 26 (!) Antibiotika. Nur Fosfomycin schien eine messbare Wirkung auf den Keim zu haben, doch das ist in den USA nur als orales Antibiotikum gegen unkomplizierte Blasenentzündung zugelassen, kann also nicht intravenös gegeben werden. Im Verlauf der Behandlung, während der die Mediziner fieberhaft nach einem Mittel gegen das Bakterium suchten, starb die Frau an einem septischen Schock. Das geschah nur zwei Wochen nach der Diagnose. Die amerikanische Gesundheitsbehörde CDC betonte, dass ein solcher panresistenter Bakterienstamm bislang sehr ungewöhnlich sei. Von den bislang mehr als 250 eingeschickten CRE-positiven Proben waren rund 80 Prozent wenigstens noch empfindlich für ein Aminoglykosid, 90 Prozent sprachen auf das Ersatzantibiotikum Tigecyclin an. Da die Frau sich diesen Keim aus einem Krankenhaus in Indien „mitgebracht“ hatte, empfahl die Behörde, jeden Patienten nach Aufenthalten und insbesondere Krankenhausaufenthalten im Ausland zu befragen und dann gegebenenfalls ein CRE-Screening durchzuführen. Die Zahlen dazu: Laut Weltgesundheitsorganisation WHO sterben allein in Europa pro Jahr 25 000 Menschen an Resistenzen. 700 000 sterben weltweit an multiresistenten Keimen. Und die Berliner Charité warnt: Bis 2050 kann sich diese Zahl auf zehn Millionen erhöhen. Als Reaktion darauf erarbeitete das Robert-Koch-Institut seit 2007 das Projekt ARS (Antibiotika-Verbrauchs-Surveillance). Eine interaktive Datenbank zur Resistenzsituation findet sich zudem auf der RKI-Webseite.
Alexandra Regner
PTA, Redaktion